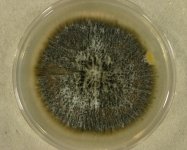

Search Details
| UAMH Number: | 8494 |
|---|---|
| Species Name: | Stilbum basitruncatum |
| Type: | Stilbum basitruncatum |
| Synonyms: | Graphium basitruncatum |
| Taxonomy: | FUNGI Ascomycota, Sordariomycetes, Hypocreales |
| Strain History: | T. Matsushima (MFC 2097) -> Nakase, T. (JCM 9300) -> UAMH |
| Substrate: | forest soil | Location: | SOLOMON ISLANDS (GEO: -9.646,160.156) |
| Isolator: | T. Matsushima (MFC 2097) |
| Isolation Date: | |
| Date Received: | 1996-06-28 |
| Characters: | SYSTEMATICS/ TAXONOMY Graphium penicillioides complex - Cruywagen EM, de Beer ZW, Wingfield MJ, Persoonia 25:61-71, 2010 // SYSTEMATICS/ TAXONOMY Graphium penicillioides complex - Kumar D, Sigler L, Gibas CFC, Mohan S, Schuh A, Medeiros BC, Peckham K, Humar A, J Clin Microbiol 45:1644-1645, 2007 // SYSTEMATICS/ TAXONOMY Graphium penicillioides complex - Okada G, Jacobs K, Kirisits T et al, Stud. Mycol. 45:169-188, 2000 (Click for publications citing UAMH 8494) |
| Compounds: | |
| Cross Reference: | CBS 320.72 // JCM 9300 // MFC 2997 // MFC-2997 |
| Collections: | Living Strains; Dried Herbarium Material |
| Pathogenic Potential: | Human: no | Animal: no | Plant: yes |
| Biosafety Risk Group: | RG1 (check the PHAC ePATHogen Risk Group Database for updates) |
| Regulatory Requirements: | Canadian requesters must provide PHAC Pathogen and Toxin License Number (see: https://www.canada.ca/en/public-health/services/laboratory-biosafety-biosecurity/licensing-program.html) prior to shipment. International requesters must provide all legally required importation documentation prior to shipment. Plant pathogenicity status may be verified by using the USDA Agricultural Research Service (ARS) Fungal Database |
| MycoBank ID: | 324204 |
| Sequences: | >UAMH08494_AB038427_ITS CCGAGTGTTTCTACTCTAAACCCACTGTGAACCTTACCACTGTCGTTGCTTCGGCGGGCGTCCGCGCCCGCCGGCAGCACCCAAACTCTTGATTTTTGTATGCCTCTCTGAGTACTAAAGACAAAACAATCAAAACTTTCAACAACGGATCTCTTGGCTGTGGCATCGATGAAGAACGCAGCGAAATGCGATAACTAATGTGAATTGCAGAATTCAGTGAATCATCGAGTCTTTGAACGCACATTGCGCCCGCTGGTATTCCGGCGGGCATGCCTGTCCGAGCGTCATTTCGTCCCTCAAGCCCCCGCGCTTGGTGTTGGGCGTCCCCGCGGGCCTTCAAGGCCGGCGGGCGCCCCAAATGCATCGGCGGTCCCGCTGGCGGCTCCCTGCGTAGTAGAATCTCTTCTCGCATCGGGTCCCGGGCGCGCGGCCAGCCGCTAAACCCCCCAATCGTACCAACGG >UAMH08494_AB007653_SSU TCATATGCTTGTCTCAAAGATTAAGCCATGCATGTCTAAGTATAAGCAATTATACCGCGAAACTGCGAATGGCTCATTATATAAGTTATAGTTTATTTGATAGCACCTTACTACATGGATAACTGTGGTAATTCTAGAGCTAAAACATGCTAAAAATCCCGACTTCGGAAGGGATGTGTTTATTAGATTAAAAACCAATGCCCTTCGGGGCTGCTTGGTGATTCATAATAACCTCTCGAATCGCACGGCCTTGCGCCGGCGATGGTTCATTCAAATTTCTTCCCTATCAACTTTCGATGCGAAGGTATTGTCTTCGCATGGTTACAACGGGTAACGGAGGGTTAGGGCTCGACCCCGGAGAAGGAGCCTGAGAAACGGCTACTACATCCAAGGAAGGCAGCAGGCGCGCAAATTACCCAATCCCGACACGGGGAGGTAGTGACAATAAATACTGATACAGGGCTCTTTTGGGTCTTGTAATTGGAATGAGTACAATTTAAATCCCTTAACGAGGAACAATTGGAGGGCAAGTCTGGTGCCAGCCAGCCGCGGTAATTCCAGCTCCAATAGCGTATATTAAAGTTGTTGTGGTTAAAAAGCTCGTAGTTGAACCTTGCNCCTGGCTGGCCGGTCCCCCTCACCGGGTGCACTGGTCCGGCCGGGCCTTTCCCTCTGTGGAACCGCATGCCCTTCACTGGGTGTGCCGGGGAAACAGGACTTTTACTTTGAAAAAATTAGAGTGCTCCAGGCAGGCCTATGCTCGAATACATTAGCATGGAATAATAGAATAGGACGTGTGGTTCTATTTTGTTGGTTTCTAGGACCGCCGTAATGATTAATAGGGACAGTCGGGGGCATCAGTATTCAATTGTCAGAGGTGAAATTCTTGGATCTATTGAAGACTAACTACTGCGAAAGCATTTTGCCAAGGATGTTTTCATTGATAAGGAACGAAAGTTAGGGGATCGAAGACGATCAGATACCGTCGTAGTCTTAACTATAAACTATGCCGACTAGGGATCGGACGGTGTTTATACTTGACCCGTTCGGCACCTTTCGAGAAATCAAAGTGCTTGGGCTCCAGGGGGAGTATGGTCGCAAGGCTGAAACTTAAAGAAATTGACGGAAGGGCCACACCAGGGGGTGGGCCTGCGGCTTAATTTGACTCAACACGGGGAAACTCACCAGGTCCAGACACAATGAGGATTGACAGATTGAGAGCTCTTTCTTGATTTTGTGGGTGGTGGTGCATGTGCCGTCTTTAGTTGGTGGAGTGATTTGTCAGCTTAATTGCGATAACGAACGAGACCTTCTTCTGCTAAATAGCCCGAACTGCTTTGGCAGTCCGCCGGCTTCCTTAGAGAGACTATGGGCTCAAGCCGATGGGAAGTTGGAGGCAATAACAGGTCTGTGATGCCCTTAGATGTTCTGGGCCGCACGCGCGCTACACTGACAGAGCCAGCGAGTATCTCCTTGGCCGAAAGGTCCGGGGTAATCTTGTTAAACTCTGTCGTGCTGGGGATAGAGCATTGCAATTATTGCTCTTCAACGAGGAATCCCTAGTAAGCGCAAGTCATCAGCTTGCGTTGATTACGTCCCTGCCCTTTGTACACACCGCCCGTCGCTACTACCGATTGAATGGCTCAGTGAGGCCTCCGGACTTGGCCCAGAGAGGTGGGTGACTACCACTCAGGGCCGGAAAGCTGTCCAAACTCGGTCATTTAGAGGAAGTAAAAGTCGTAACAAGGTCTCCGTT |
IMAGES: